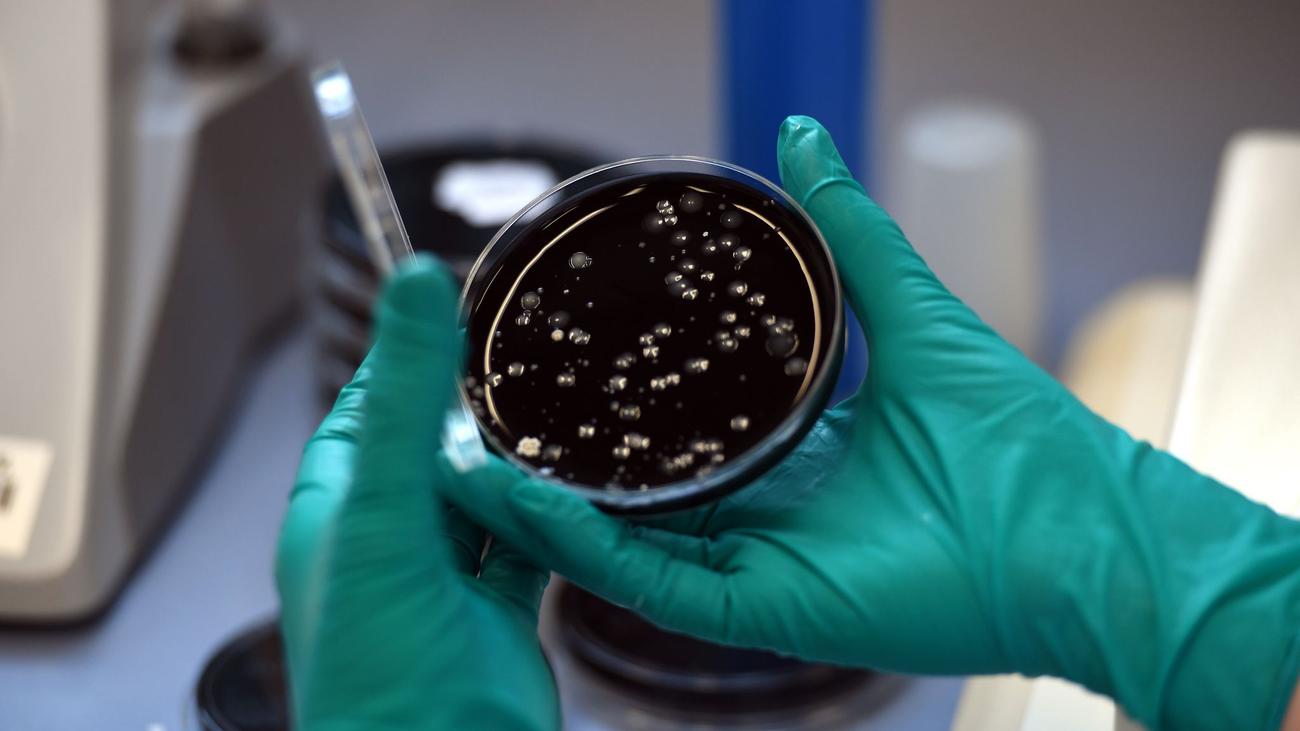
Nach Fußpflege gestorben: Zwei Tote nach Legionellen in Salon – Betreiberin entlastet

an hour ago von Zeit.de
Mobilität: Staatsschutz ermittelt nach Kabelschaden am Gelsenkirchener Bahnhof

Unbekannte haben in der Nacht Kabel in Gelsenkirchen beschädigt. In Teilen des Ruhrgebiets war der Bahnverkehr zeitweise unterbrochen, die Ermittlungen laufen.
Weiter zum Artikel